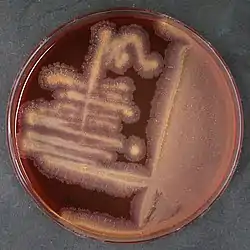

Tsukamurella serpentis
Tsukamurella serpentis es una bacteria grampositiva del género Tsukamurella. Fue descrita en el año 2016. Su etimología hace referencia a serpiente.[1] Es aerobia, inmóvil, catalasa positiva y oxidasa negativa. Crece en agar sangre con colonias amarillas, irregulares. También crece en agar infusión cerebro corazón, TSA, agar chocolate y MacConkey. Temperatura óptima de crecimiento de 25 °C, crece a 10 °C pero no a 42 °C. Se ha aislado de la cavidad oral de cobras chinas (Naja atra) en Hong Kong.
| Tsukamurella serpentis | ||
|---|---|---|
![]() Tsukamurella serpentis | ||
| Taxonomía | ||
| Dominio: | Bacteria | |
| Filo: | Actinomycetota | |
| Clase: | Actinomycetes | |
| Orden: | Mycobacteriales | |
| Familia: | Tsukamurellaceae | |
| Género: | Tsukamurella | |
| Especie: |
Tsukamurella serpentis Tang et al. 2016 | |
Referencias
- Tang, Ying; Teng, Jade L. L.; Cheung, Candy L. W.; Ngan, Antonio H. Y.; Huang, Yi; Wong, Samson S. Y.; Yip, Eric K. T.; Ng, Kenneth H. L. et al. (2016-09). «Tsukamurella serpentis sp. nov., isolated from the oral cavity of Chinese cobras (Naja atra)». International Journal of Systematic and Evolutionary Microbiology 66 (9): 3329-3336. ISSN 1466-5034. PMID 27257031. doi:10.1099/ijsem.0.001187. Consultado el 13 de agosto de 2022.
Este artículo ha sido escrito por Wikipedia. El texto está disponible bajo la licencia Creative Commons - Atribución - CompartirIgual. Pueden aplicarse cláusulas adicionales a los archivos multimedia.